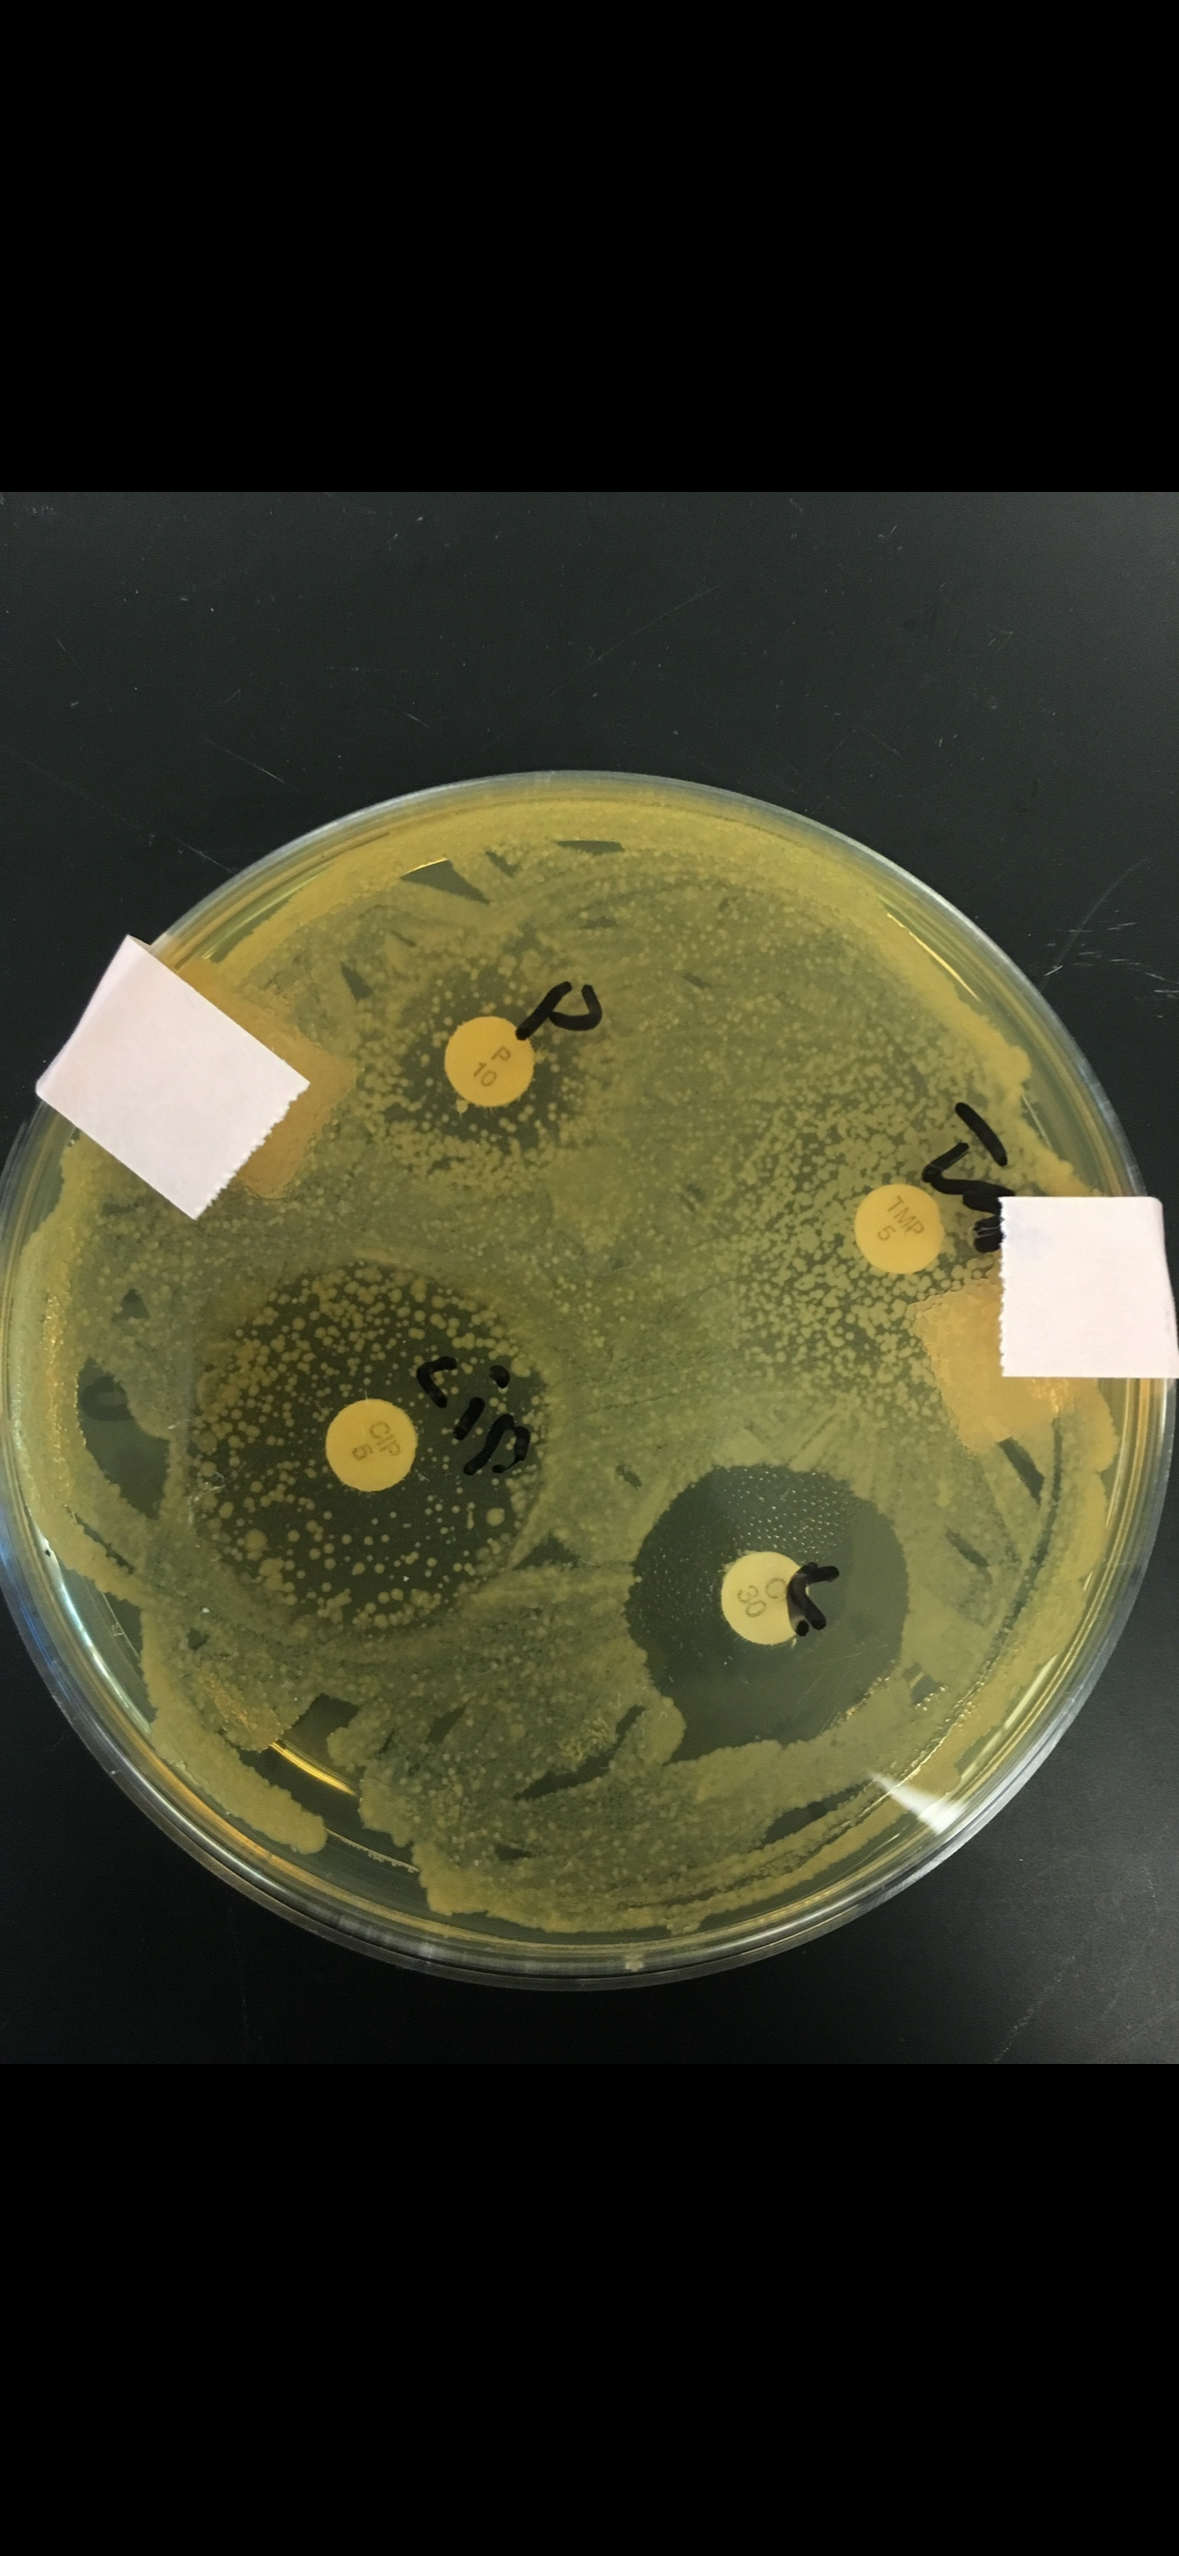

JD Life-Tech
The S.T.E.A.M.M.M.
Company
Science, Technology, Engineering, Art, Music, Mathematics, and Medicine
Whether you want to collaborate on a project, explore a contract, inquire about JD Life-Tech tailoring a product or service to your needs or need help on your existing project—JD Life-Tech is here to help.
If JD Life-Tech does not do it, then we might be able direct you to the proper channels or team.

Contact JD Life-Tech at
jake@jdlifetech.org
Our Services
S.T.E.A.M.M.M.

About JD Life-Tech
JD Life-Tech is the S.T.E.A.M.M.M. company.
S.cience, T.echnology, E.ngineering, A.rt, M.usic, M.athematics, and M.edicine
This business operates in a multitude of industries providing tailored services to artists, industry professionals, scientists and creating products for professionals and consumers.
JD Life-Tech develops and runs its own programs and jobs. The company also assists industry professionals with their projects in numerous industry spaces.
S.cience
The heart of ability lies in science.
Whether we are conversing about bioengineering and recombinant organism creation, genetic modification, electrical engineering, sound science, medical devices, computer science, hardware, or the science of music—JD Life-Tech creates it, uses it and furthers scientific progression.
Science is Power.




Every event we host is designed with intention, from the atmosphere we create to the way each session flows.









T.echnology
JD Life-Tech builds it.
JD Life-Tech uses it.
JD Life-Techs creates it.
JD Life-Tech creates with it.
Every event we host is designed with intention, from the atmosphere we create to the way each session flows.




Technology is the hardware that grants operational ability.





E.ngineering
JD Life-Tech pioneers novel products in engineering industries.
Bioengineering: Disease deactivation by genetic recombination
Biotechnology: The devices that allow us to bioengineer
Electrical Engineering: Electron movement, magnetic field orientation, and power direction
Automotive: mechanics, repairs, work, replacements
Quantum Mechanics: Mathematics is great. But functional mathematics is better. The science of information orientation, movement and superposition all the way down to a subatomic level.
Software Engineering: Program creation (For software and hardware) with backend in languages such as C++, Python, Javascript, R, TypeScript, HTML in projects such as app development, website creation, virtual builders and API (Application programming interface) development.
Sound Engineering: Engineering instruments and working sound design in software programs. Whether recording live sound or editing a mixed or mastered track, JD Life-Tech wants to make it appealing to our ears.








A.rt
At the Heart of every project is Art.

The Art of Instrument creation
The Art of Music Creation
The Art of Bioengineering
The Art of Hardware Design
The Art of Software Design
The Art of Integration and Orientation
The Art of Script Writing and Character Development in theater and movies
And we cannot forget….2 Dimensional Visual Art

M.usic
JD Life-Tech is partnered with over 30 leading businesses in the music industry.
JD Life-Tech ascertains responsibilities including: instrument development, song writing, sound design, sound recording, sound mixing and mastering, and music publication.
JD Life-Tech Specialties:
Song writing (music and lyrics)
Vocals, piano, guitar, percussion, bass, and more!
Guitar build, creation, remodel, refinish
Raw, live recording methods for publishable music
Music mixing and mastering with a focus in Logic ProX
Music theory
Novel music theory creation
Project collaboration
With released music around the world, JD Life-Tech has dozens of songs being prepared for publishing






With access to professional grade studios, JD Life-Tech also is equipped with a mobil recording studio to meet artists where they are and record almost anywhere.
M.athematics
Mathematics is logistics driving.
The math on paper does not always translate into functional mathematics.
JD Life-Tech focuses on functional mathematics in computer science, software and hardware programming, electrical engineering, quantum mechanics and system assessment for computational capacity.
JD Life-Tech assesses the viability of a task by considering the math of all pertinent factors and sciences.







Not only is JD Life-Tech mathing original projects but has assessed facets of the United States Economy including its integration into virtual systems.
JD Life-Tech has assessed the operational mathematic abilities of United States brokerages.
JD Life-Tech has also done light assessment on economics for 23 countries in relation to the United States economy.
Most Importantly: JD Life-Tech understanding YOUR economy whether it is the economy of your person or your business, JD Life-Tech prioritizes understanding YOU.
We do not want math to hold you back!
M.edicine
JD Life-Tech aims to power LIFE.
With a background in Biology, Biotechnology, And Bioengineering—JD Life-Tech pioneers its own projects and assists existing developers and businesses with their ongoing projects.
JD Life-Tech has run bioengineering projects in disease deactivation of food-borne pathogens such as Salmonella enterica. Killing a disease is one thing and very important but neutralizing it and turning a pathogen into a living non-pathogen brings whole new benefits!
This has been accomplished through genetic recombination and deactivation of cellular phenotype structures via gene deletion.
JD Life-Tech has also accomplished selected phenotypic exhibition of cellular traits in non-pathogens by incorporation of exogenous genetic material.


JD Life-Tech prioritizes health!
Build a healthy body and a healthy life!

JD Life-Tech has also worked for and assisted established business in the medical industry.
Some past projects JD Life-Tech worked on or assisted with:
Component manufacturing of parts of Abiomed’s Impella Heart pump, the world’s smallest heart pump.
Prospective Research’s antibiotic discovery and rediscovery via soil cultured Streptomycete bacteria.
MilliporeSigma order processing and kit assembly of components for devices used in the medical industry.
And More!
Are you interested or in need?
Contact JD Life-Tech regarding:
Assistance for your ongoing project
Project Collaborations
Contracts
A JD Life-Tech product or service made specifically to meet your needs
Upcoming JD Life-Tech music
Contact:
jake@jdlifetech.org
